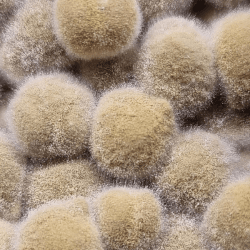
Koji on line webinar Koji on line webinar

Koji, aglio nero, garum: tecniche, ricette e ingredienti. Masterclass on line!
Con Limone nero ed ossidazioni enzimatiche
12-13-14 Gennaio 2026
Il primo percorso in Italia interamente dedicato a tamari, garum, salse amminiche, aglio nero e limone nero sempre accessibile online. Un'opportunità unica per imparare come si fa l’aglio nero, scoprire ricette con aglio nero e padroneggiare la produzione di koji e garum, anche in versione vegetale o senza soia e glutine. In tre giorni, seguiti passo passo dal docente, imparerai a realizzare in sicurezza salse fermentate come lo shoyu e il garum di parmigiano, esplorando gli ingredienti essenziali del koji e del garum e sviluppando competenze pratiche per diventare autonomo nella produzione. Un concentrato di anni di esperienza sperimentale, ora a tua disposizione.




Non servono attrezzature particolari: il metodo spiegato nel corso è pensato per permetterti di produrre shoyu o tamari in casa, con ciò che hai già a disposizione. Le tecniche sono semplici, pratiche e accessibili, anche per chi parte da zero. Se vorrai, ti mostreremo anche strumenti più tecnici per accelerare la produzione e ottenere un garum ancora più efficiente.
Scoprirai come utilizzare il koji per realizzare garum di pollo, garum di manzo, o anche versioni vegetali, partendo da ingredienti naturali facilmente reperibili. Un focus speciale sarà dedicato all’umami dell’aglio nero, con ricette, applicazioni e indicazioni pratiche.
Il corso si svolge in diretta ed è acquistabile solo fino al 10 gennaio 2026.
⚠️ Edizione unica per il 2026 – la prossima sarà nel 2027.
👇 Scorri per leggere il programma completo!
Programma del corso – 3 giornate intensive sulla fermentazione e la produzione di salse umami
Giorno 1 – La base del gusto: cereali, legumi e koji
Iniziamo con la scelta consapevole del legume e del cereale, esplorando le caratteristiche aromatiche che influenzano le salse finali. Imparerai l’ammollo, i diversi metodi di cottura, l’inoculo del koji e la gestione delle temperature durante l’incubazione.
Analizzeremo le differenze tra Shoyu koji, Tamari koji e koji per garum, con un focus sugli ingredienti koji garum e come ottenere il massimo dell’umami anche senza soia o glutine.
Giorno 2 – Dalla teoria alla pratica: shoyu, tamari e garum
Controllo dei processi in corso: verificheremo lo stato di avanzamento del tuo shoyu/tamari/garum koji. Approfondiremo la gestione di temperatura e umidità, fondamentali per la riuscita.
Dedicheremo spazio alla teoria del garum, incluso come realizzare un garum di pollo, un garum di manzo o un garum di parmigiano, partendo da ingredienti accessibili.
Imparerai a scegliere tra fermentazione a temperatura ambiente o controllata, con esempi pratici sugli strumenti utili per entrambe le opzioni.
Giorno 3 – La fermentazione prende forma
Valuteremo insieme i risultati ottenuti e analizzeremo eventuali problemi di produzione. Avvieremo la fermentazione dei tuoi primi batch di Shoyu, Tamari e Garum vegetale da stagionare.
Vedremo come gestire le salse nel tempo, anche con strumenti tecnici (opzionali) per migliorare l’efficienza.
In questa fase, introdurremo anche l’utilizzo dell’aglio nero, spiegando come si fa l’aglio nero, come inserirlo nelle ricette, e come valorizzarne il potente umami aglio nero all’interno delle tue fermentazioni.
👉 Potrebbero essere previste giornate extra di approfondimento, sempre registrate e disponibili per tutti gli iscritti.
In questo corso imparerari a fare:
- Shoyu (la classica salsa di soia) anche senza glutine e soia
- Tamari (anche senza soia)
- Garum di pesce
- Garum di lievito
- Garum di pomodori
- Garum di funghi e di verdure
- Garum di Parmigiano
- Aglio nero e frutta nera (limone, mela, castagne)
- Gestire le temperature per accelerare la produzione di tutte queste cose
Valore del webinar
79,00€
Hai domande, vuoi informazioni che non trovi nella descrizione? Scrivimi!
Koji, aglio nero, garum: tecniche, ricette e ingredienti. Masterclass on line!
Con Limone nero ed ossidazioni enzimatiche
12 - 13 - 14 gennaio 2026
Il primo percorso in Italia interamente dedicato a tamari, garum, salse amminiche, aglio nero e limone nero sempre accessibile online. Un'opportunità unica per imparare come si fa l’aglio nero, scoprire ricette con aglio nero e padroneggiare la produzione di koji e garum, anche in versione vegetale o senza soia e glutine. In tre giorni, seguiti passo passo dal docente, imparerai a realizzare in sicurezza salse fermentate come lo shoyu e il garum di parmigiano, esplorando gli ingredienti essenziali del koji e del garum e sviluppando competenze pratiche per diventare autonomo nella produzione. Un concentrato di anni di esperienza sperimentale, ora a tua disposizione.




Non servono attrezzature particolari: il metodo spiegato nel corso è pensato per permetterti di produrre shoyu o tamari in casa, con ciò che hai già a disposizione. Le tecniche sono semplici, pratiche e accessibili, anche per chi parte da zero. Se vorrai, ti mostreremo anche strumenti più tecnici per accelerare la produzione e ottenere un garum ancora più efficiente.
Scoprirai come utilizzare il koji per realizzare garum di pollo, garum di manzo, o anche versioni vegetali, partendo da ingredienti naturali facilmente reperibili. Un focus speciale sarà dedicato all’umami dell’aglio nero, con ricette, applicazioni e indicazioni pratiche.
Il
corso si svolge in diretta ed è acquistabile solo fino al
10 gennaio 2026.
⚠️ Edizione unica per il
2026 – la prossima sarà nel 2027.
👇 Scorri per leggere il
programma completo!

Programma del corso – 3 giornate intensive sulla fermentazione e la produzione di salse umami
Giorno 1 – La base del gusto: cereali, legumi e koji
Iniziamo con la scelta consapevole del
legume e del cereale, esplorando
le caratteristiche aromatiche che influenzano le salse finali.
Imparerai l’ammollo, i diversi metodi di
cottura, l’inoculo del koji e la gestione
delle temperature durante
l’incubazione.
Analizzeremo le differenze tra
Shoyu koji, Tamari koji e
koji per garum, con un focus sugli ingredienti
koji garum e come ottenere il massimo dell’umami anche senza
soia o glutine.
Giorno 2 – Dalla teoria alla pratica: shoyu, tamari e garum
Controllo dei processi in corso: verificheremo
lo stato di avanzamento del tuo shoyu/tamari/garum koji.
Approfondiremo la gestione di temperatura e
umidità, fondamentali per la riuscita.
Dedicheremo spazio alla teoria del
garum, incluso come realizzare un garum di
pollo, un garum di manzo o un
garum di parmigiano, partendo da ingredienti
accessibili.
Imparerai a scegliere tra
fermentazione a temperatura ambiente o
controllata, con esempi pratici sugli strumenti utili per
entrambe le opzioni.
Giorno 3 – La fermentazione prende forma
Valuteremo insieme i risultati ottenuti e
analizzeremo eventuali problemi di produzione. Avvieremo la
fermentazione dei tuoi primi batch di Shoyu,
Tamari e Garum vegetale da
stagionare.
Vedremo come gestire le salse nel
tempo, anche con strumenti tecnici (opzionali) per migliorare
l’efficienza.
In questa fase, introdurremo anche
l’utilizzo dell’aglio nero, spiegando come si
fa l’aglio nero, come inserirlo nelle
ricette, e come valorizzarne il potente
umami aglio nero all’interno delle tue
fermentazioni.
👉 Potrebbero essere previste giornate extra di approfondimento, sempre registrate e disponibili per tutti gli iscritti.
In questo corso imparerari a fare:
- Shoyu (la classica salsa di soia) anche senza glutine e soia
- Tamari (anche senza soia)
- Garum di pesce
- Garum di lievito
- Garum di pomodori
- Garum di funghi e di verdure
- Garum di Parmigiano
- Aglio nero e frutta nera (limone, mela, castagne)
- Gestire le temperature per accelerare la produzione di tutte queste cose
Valore del webinar